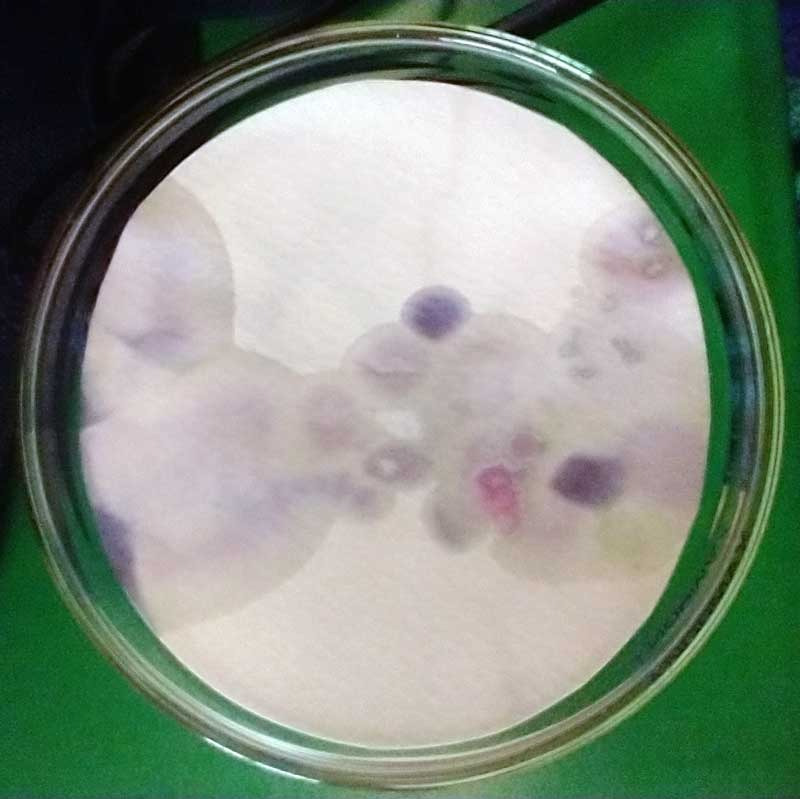
Petri

Horizontes Verjonitas
El Verjón se ubica en la Reserva Forestal Protectora Bosque Oriental de Bogotá, un área de gran importancia estratégica para la conectividad de los páramos de oriente (Chingaza, Cruz Verde y Sumapaz).
En la actualidad este territorio afronta presiones urbanizadoras y de gentrificación que ponen en riesgo la conservación de este puente de conectividad ecológica. Por esta razón es tan importante fortalecernos como comunidad verjonita desde la comprensión de lo que significa vivir en compañía de todos los demás vecinos multiespecie que nos acogen en esta montaña.
Micro/Macro


En el último año nos hemos concentrado en el encuentro micro/macro con los líquenes, unos organismos que nos enseñan acerca de la complejidad de las relaciones simbióticas entre hongos, algas y bacterias. Una de las principales inspiraciones en este encuentro con los líquenes son la serie de ensayos Twelve Readings on the Lichen Tallus del naturalista y artista botánico Trevor Goward, que expone una interesante conversación en el cruce del arte y la biología.
Goward nos dice: "Los líquenes existen en una especie de umbral conceptual. Cuando miramos a través del microscopio, lo que vemos es multiplicidad: el liquen en sus partes, como hongo, como alga, como simbiosis, como ecosistema. Pero cuando miramos en la otra dirección, a escala macro, lo que entra en foco ahora es la unidad: el liquen como propiedad emergente, como entidad fisiológica, como organismo".








Diseñamos y construimos un microscopio hecho en cartón, que utiliza Raspberry Pi y ópticas acromáticas. Esta herramienta convivencial nos ayuda a registrar nuestras exploraciones en el mundo de los líquenes. Este acercamiento micro/macro nos ha llevado a explorar la complejidad ecológica de los líquenes desde la estética propia de su morfología. Hasta el momento hemos identificado 52 biotipos diferentes de tipo costrosos, fructicosos y lignícolas.
Niebla


Nos hemos acostumbrado a pensar en los páramos como supuestas 'fabricas de agua', lo cual no es así. Los páramos son de los últimos ecosistemas en evolucionar, y son constituidos por relaciones muy delicadas que necesitan de flujos continuos entre los diferentes organismos y el entorno. Las pequeñas plantas ericáceas que habitan los páramos y los bosques alto andinos se han adaptando desarrollando superficies texturadas llenas de vellosidades, espinas o escamas con el fin de recolectar gota a gota la humedad que se desplaza por el aire en forma de niebla. El agua que el páramo atesora no es algo que emerge de su suelo, sino el producto de una constante recolección de micro-gotas, que muy poco a poco van creando gotas de rocío, pequeños charcos, pocetas, lagunas y quebradas.


La niebla es esencial en el ecosistema andino. Esta se forma gracias a corrientes de aire húmedo que desde la amazonía se elevan hacia las montañas alto andinas. El aire asciende y al enfriarse el vapor de agua se condensa en micro-gotas. Estas gotas permanecen suspendidas cerca del suelo creando una capa de niebla que se mantiene durante horas o incluso días.
A su vez, para que las esporas puedan ser expulsadas de las lamelas de los hongos estos necesitan de la colaboración de micro-gotas que cambien su punto de equilibrio y las propulsen fuera. Así, la esporación proveniente de los bosques alto andinos es la que permite la formación de la niebla en la montaña, siendo a su vez esta niebla la que hace posible la esporación en el bosque. ¡Un ciclo perfecto!
LAV


Desde el LAV (Laboratorio de Artes Verjonitas) nos acercamos a la reflexión estética y la exploración estocástica de las manchas liquénicas y las micro-gotas de niebla.
Este espacio propone la idea de que esta es una exploración estética basada en el errar —de ir hacia otro lugar—, donde asumimos la aproximación que John Cage hace al arte dejándonos llevar por la "gracia generativa del azar y el accidente". Utilizamos tintes naturales hechos por nosotros mismos con frutos, hojas y tallos de plantas locales de El Verjón, así como arcillas presentes en el mismo territorio. El instrumental hace eco a los laboratorios de investigación micro-biológica, dándole un giro de creación visual.








En el laboratorio nos acercamos al drip painting, el soak-stain y el color field painting inspirados en los trabajos de artistas contemporáneos.

Mapeo


Lo expuesto por Gregory Bateson acerca de que "el mapa es el territorio" nos ha llevado a configurar una serie de mapas mhiceliares que experimentan con resonancias visuales de las relaciones complejas que se dan en los paisajes nubo-liquénicos de El Verjón.
Para el mapeo hemos partido del estudio visual de la morfología de los líquenes, navegando sus texturas y geometrías como una manera de acercarnos a estos organismos complejos. Pero pronto nos dimos cuenta de la vitalidad de su movimiento, en especial en interacción con la niebla, el rocío y la lluvía. Así que, retomando algunos conceptos de la Gestalt, iniciamos iteraciones de transposición visual de las manchas liquénicas experimentando con la inversión como concepto y técnica.




Con esto buscamos poco a poco transformar nuestra percepción del fondo ecológico que habitualmente pasamos desapercibido, yendo más allá de la forma hacia figuras vitales que nos generan curiosidad y pregunta sobre el mundo multiespecie del que hacemos parte.
Proceso realizado gracias a la alianza de:
